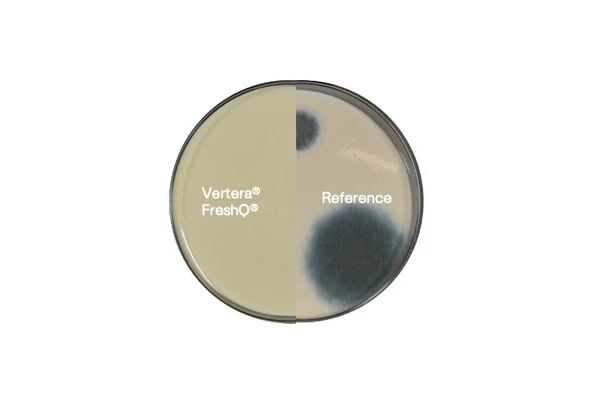
Vertera Fresh

Fermentation-enabled bioprotection for fresher vegurts
By naturally delaying the outgrowth of yeast and mold, our bioprotective cultures deliver fermentation-enabled bioprotection to help extend shelf life and keep your vegurts fresh for longer.
Yeast and mold: the challenge
Consumers want vegurts that stay fresh and delicious to the last spoonful. High levels of yeast and mold cause visible spoilage in vegurts, while low-level growth can create off-flavors and odors even under optimal storage conditions. Novonesis Vertera® FreshQ® bioprotective cultures help protect quality and fresh taste throughout shelf life.

Vertera® FreshQ® for better, longer-lasting vegurts
Take control
Consumers rarely complain about spoiled products. They just stop buying and may warn others. Recalls can damage retailer relationships and attract negative media. Take control of yeast and mold with Vertera® FreshQ®, which delivers fermentation-enabled bioprotection to help slow the growth of spoilage microorganisms.

Extend shelf life
Imagine being able to support extended shelf life naturally, without compromising on consumer demand for food with simple labels. Vertera® FreshQ® uses fermentation-enabled bioprotection to help extend freshness, enhance production efficiency, and keep your products the preferred choice on the shelf.

Go natural
Improving quality and consistency naturally boosts product appeal as consumers seek simple, recognizable ingredients. Vertera® FreshQ® can be added to vegurts without lengthening the ingredient list.

Stay fresh
Keep your products tasting as intended, delivering the quality consumers expect. Vertera® FreshQ® bioprotective cultures help maintain flavor and freshness, even with broken cold chains and opened packaging.

Make it sustainable
Wasted food is an economic and environmental burden. Vertera® FreshQ® helps protect your investment in sustainability by enabling you to reduce food waste across the value chain.

Vertera® FreshQ® works across plant-bases
We tested Vertera® FreshQ® in various plant-based yogurts, comparing each base with and without the culture. In one example, a coconut base was spiked with mold that causes spoilage in plant-based yogurts.
The results were clear: the fermentation-enabled bioprotection of Vertera® FreshQ® delayed mold outgrowth.
Reference test
Fermented coconut bases made with or without the addition of Vertera® FreshQ® 101 (100U/T) added Penicillium brevicompactum (500 spores) and stored at 7˚C
Ready to unlock the answers from inside?
Fill out the form below and one of our plant-based food experts will be in touch shortly.
One more step…
To complete the get in touch form or sign up, please click on the button below to enable cookies.
